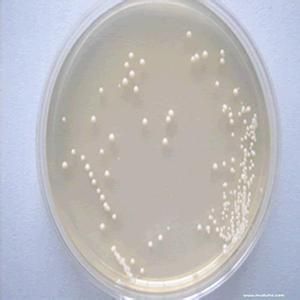
糞便培養 糞便培養

概述
糞便培養糞便是人體消化系統自口腔中攝人食物,經過胃、腸一系列消化吸收後,排出體外的食物殘渣。它的形態、顏色、成分可直接反映出人體整個消化系統(包括胃、十二指腸、肝、膽,空腸、迴腸)的功能是否健全、有無異常或局部感染病灶等。
正常值
正常大便中應有大量的細菌,但主要是大腸桿菌,它是腸道的主要寄生菌,同時它形成了一個正常菌群,其作用主要是:
①維護腸功能的消化吸收功能;
②抵禦外細菌。
臨床意義
作大便培養檢查的意義在於糞便是否以大腸桿菌為主,否則為菌群失調。在菌群失調狀況下應準確和儘快檢測出主要致病菌是什麼,及早期使用抗生素,調整菌群。糞便中主要致病菌並導致的疾病有:
(1)沙門氏菌屬可導致傷寒病;
(2)志賀氏菌屬可導致痢疾病;
(3)大腸桿菌O157菌可導致出血性腸炎;
(4)霍亂弧菌可導致霍亂病;
(5)金黃色葡萄球菌可導致化膿性腸炎;
(6)變形桿菌等可導致急性腸炎;
(7)白色念珠菌等可反映出抗生素使用過量,應儘快停止使用抗生素。
由此可見,糞便檢查培養的臨床意義很大,它直接反應了人體消化系統的各器官功能,及一些傳染病的爆發源。
糞便培養標本的採集
目的
檢查糞便中的致病菌。
用物
糞便培養瓶、清潔便盆、無菌竹籤。
步驟
1.查對醫囑,貼附聯於便盒上。
2.核對病人,解釋留便目的及方法。
3.囑病人排空膀胱後,解便於清潔便盆內。
4.用無菌竹籤取中央部分或帶膿血、粘液的糞便少許,置於培養瓶內。
5.及時送檢。